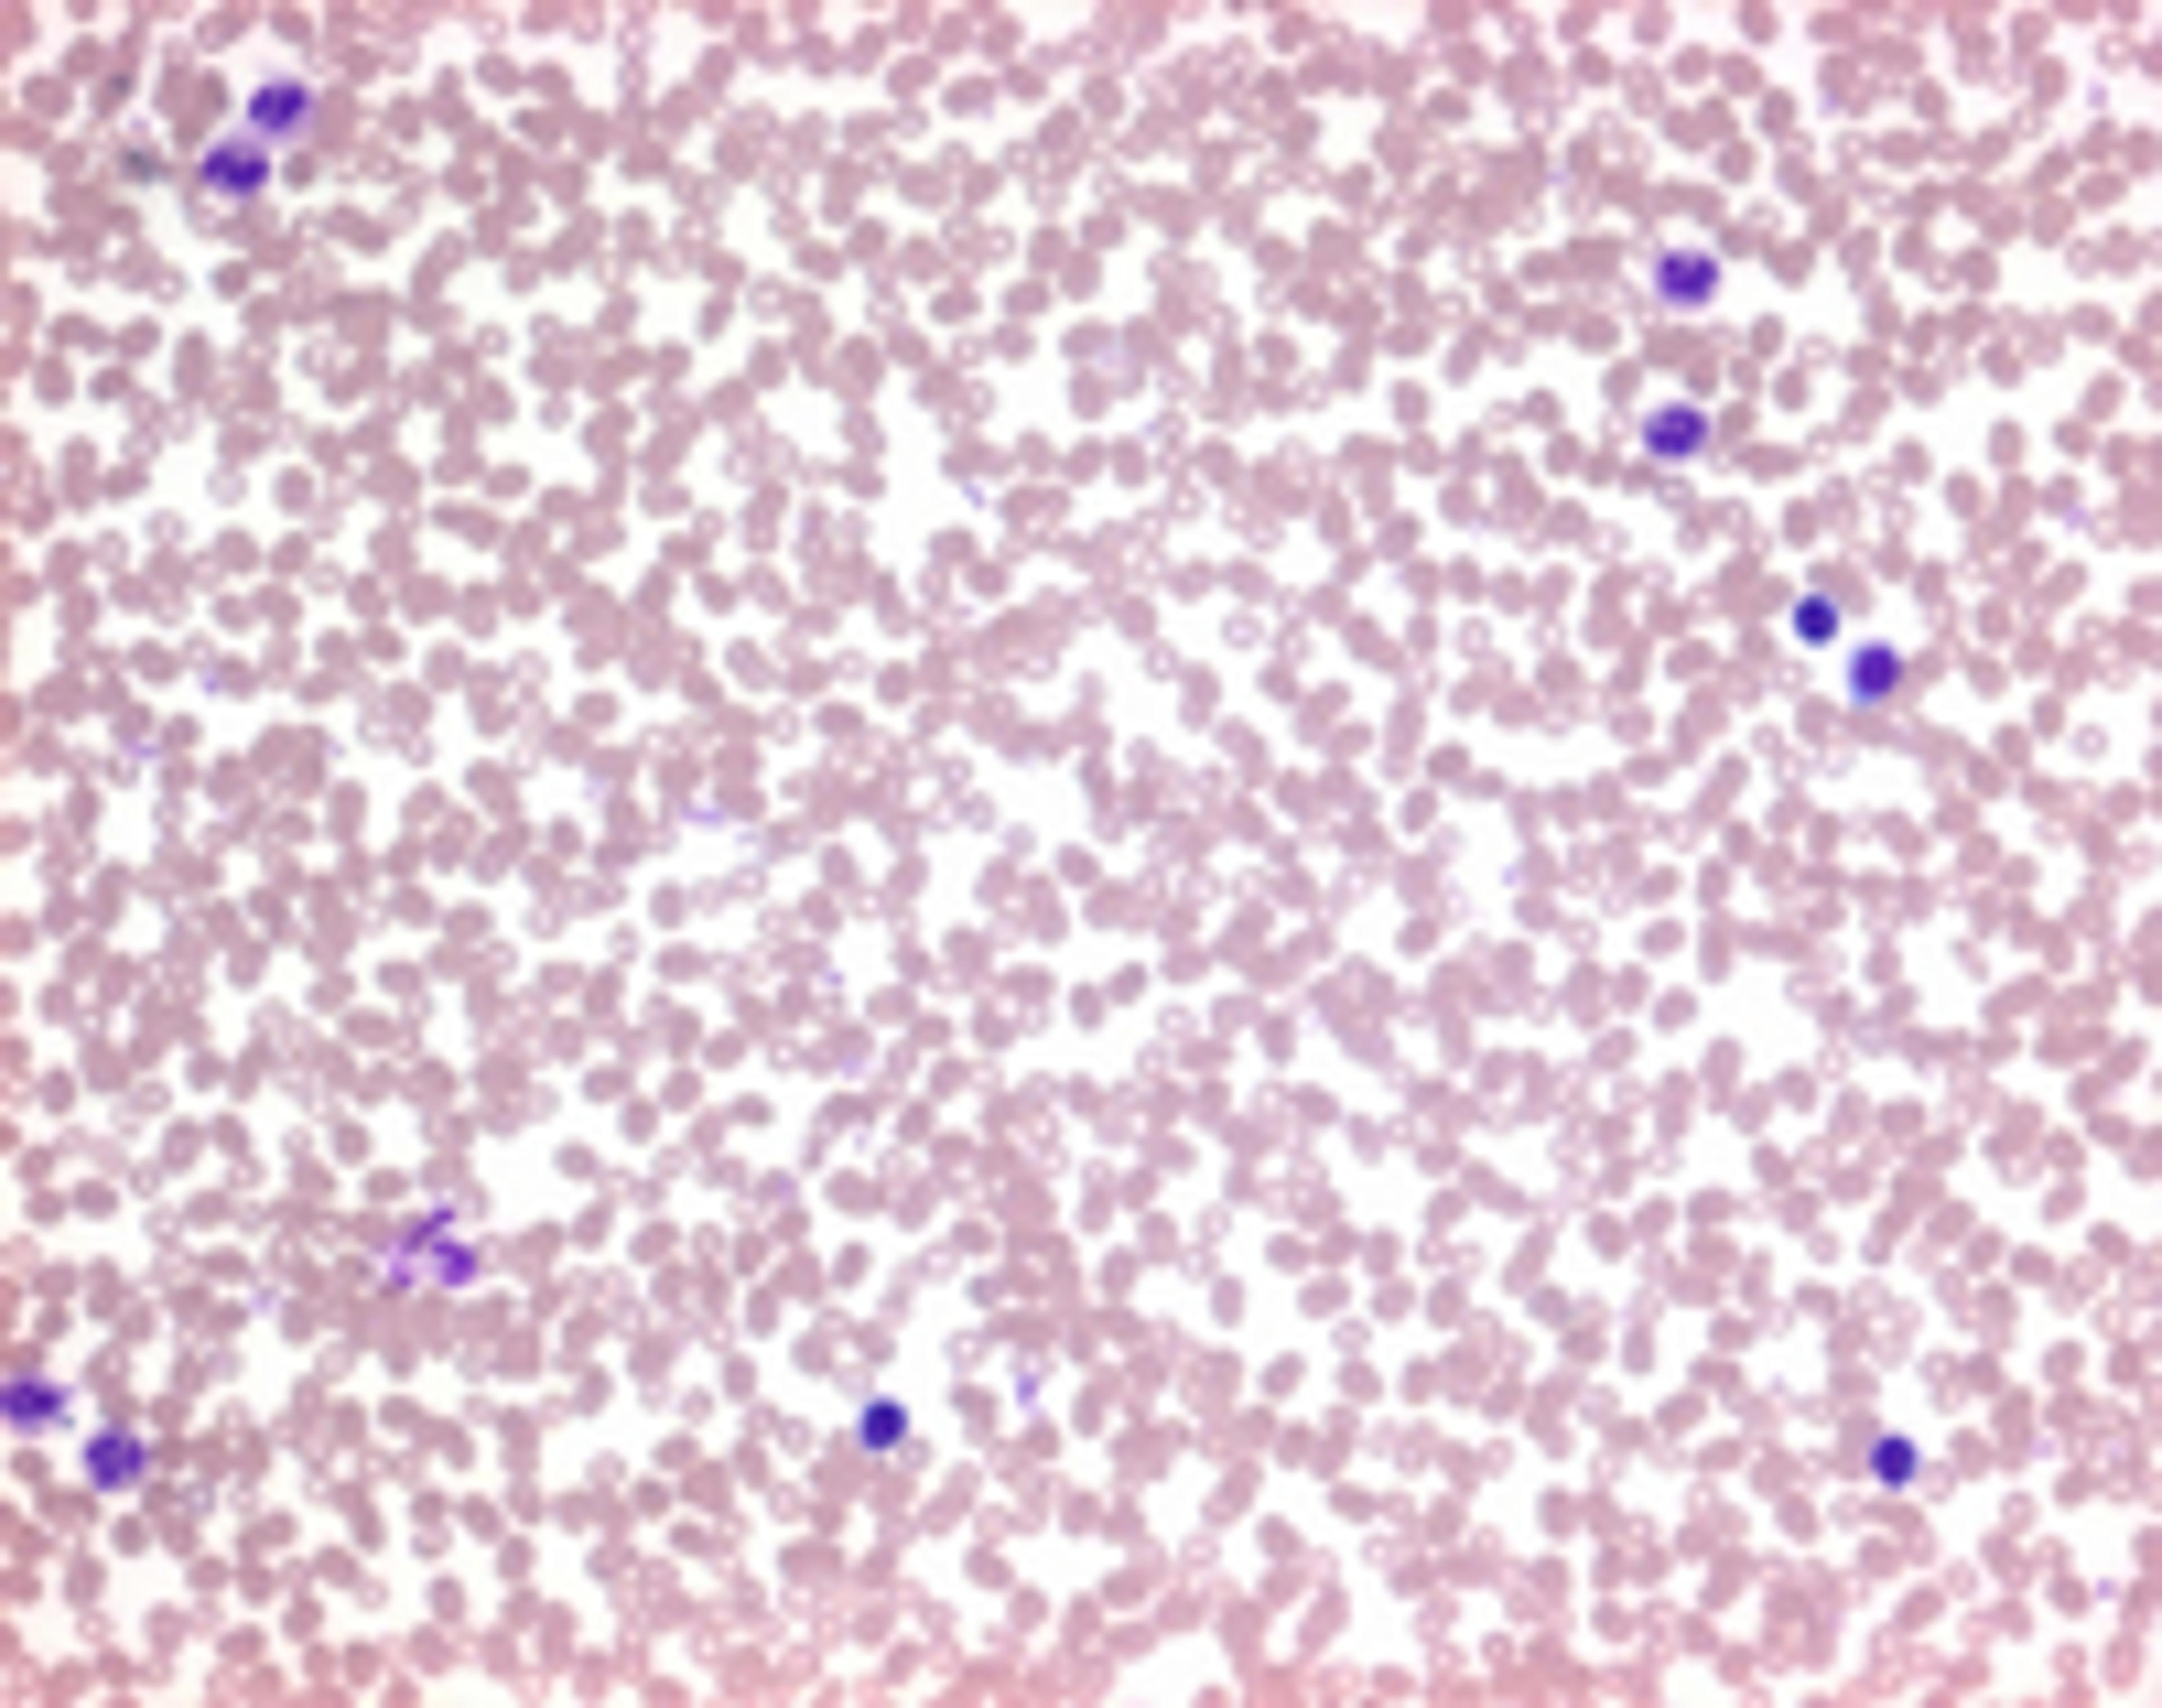
Auto-Hemacolor® - Merck KGaA, Darmstadt, Germany - Clinical Diagnostics

Singlepath® Listeria Lateral Flow Tests
Merck KGaA, Darmstadt, GermanyMerck Millipore’s Singlepath® Lateral Flow Tests are immunoassays for detecting pathogens with the ultimate convenience. Covering the major pathogens, the tests act as mini-laboratories in the “pregnancy test” format and always include a built-in control reaction. Another major advantage is that they deliver definite results as little as 20 minutes after sample enrichment.Merck Millipore Lateral Flow Tests offer all the benef…